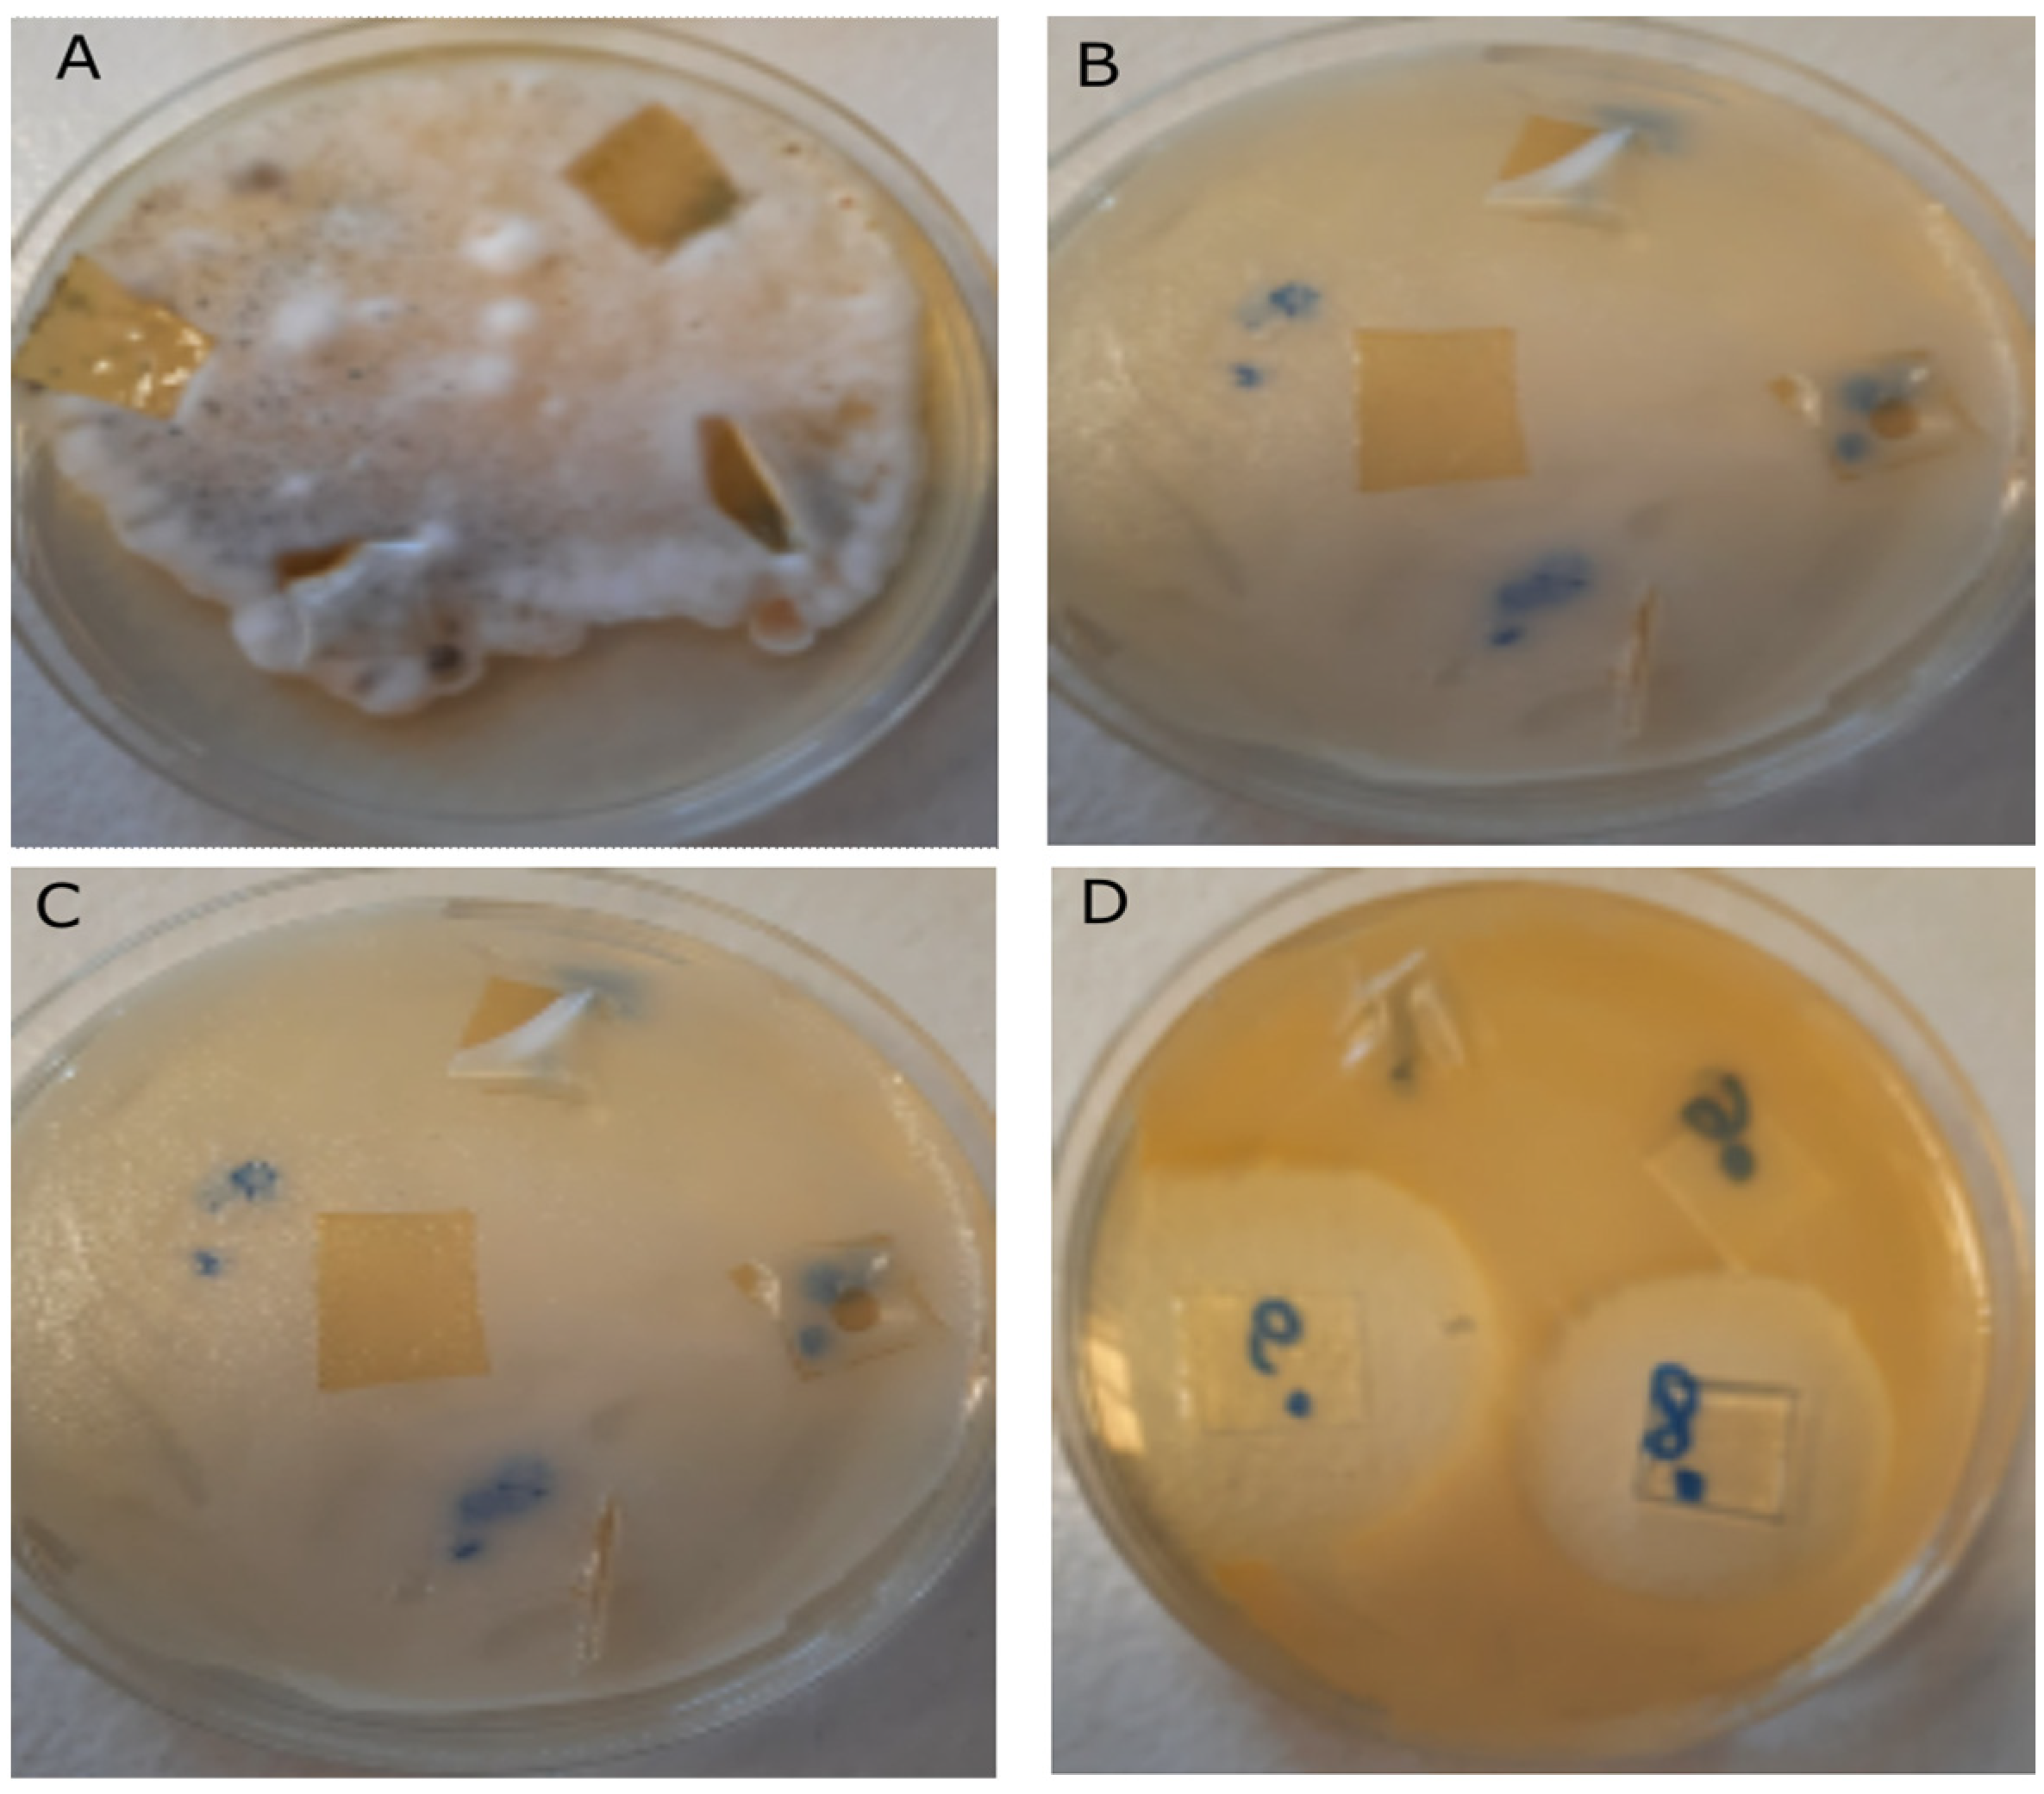

Synthesis and Characterization of Antibacterial Chitosan Films with Ciprofloxacin in Acidic Conditions
Abstract
:1. Introduction
2. Results
2.1. FTIR-ATR Analysis
2.2. Solid-State NMR Studies
2.3. AFM Analysis
2.4. SEM Image Analysis
2.5. Analysis of CIP Adhesion on Surface of Chitosan Discs
2.6. Analysis of Antibacterial and Antifungal Activity of CIP-Chitosan Adduct in Film Form
3. Materials and Methods
3.1. Preparation of Chitosan Solutions—Substrates for Obtaining Chitosan Films
3.2. GPC/SEC Analysis—Determination of Molecular Weight of Chitosan
3.3. Preparation of Chitosan Films
3.4. Modification of Chitosan Films by Acetic Acid Vapor Treatment
3.5. Modification of Chitosan Films with CIP—Procedure of Coating Discs (Preparation of Physical Adducts of Chitosan and CIP)
3.6. Quantitative Assessment of CIP Content in Physical Chitosan-CIP Adduct by Using RP-HPLC Method
3.7. Analysis of Surface of Physical Adduct of CS-CIP by AFM Method
3.8. Analysis of Surface of Physical Adduct of CS-CIP by SEM Method
3.9. Analysis of Physical Adduct of CS-CIP and CS-CIP Films Treated with Acetic Acid Vapors by FTIR Method
3.10. Analysis of Physical Adduct of CS-CIP by NMR Method
3.11. Assessment of Antimicrobial Activity of Physical Adduct of CS-CIP and CS-CIP Films Treated with Acetic Acid Vapors
3.12. Additional Analysis of Determination of Degree of Deacetylation of Chitosan 1H-NMR Spectroscopy—Figures and Table Are in Supplementary Materials Section
4. Conclusions
Supplementary Materials
Author Contributions
Funding
Data Availability Statement
Conflicts of Interest
References
- Wu, Z.L.; Zhao, J.; Xu, R. Recent advances in oral nano-antibiotics for bacterial infection therapy. Int. J. Nanomed. 2020, 15, 9587–9610. [Google Scholar] [CrossRef] [PubMed]
- Teno, J.; Pardo-Figuerez, M.; Figueroa-Lopez, K.J.; Prieto, C.; Lagaron, J.M. Development of Multilayer Ciprofloxacin Hydrochloride Electrospun Patches for Buccal Drug Delivery. J. Funct. Biomater. 2022, 13, 170. [Google Scholar] [CrossRef] [PubMed]
- Huan, Y.; Kong, Q.; Tang, Q.; Wang, Y.; Mou, H.; Ying, R.; Li, C. Antimicrobial peptides/ciprofloxacin-loaded O-carboxymethyl chitosan/self-assembling peptides hydrogel dressing with sustained-release effect for enhanced anti-bacterial infection and wound healing. Carbohydr. Polym. 2022, 15, 280. [Google Scholar] [CrossRef] [PubMed]
- Motiei, M.; Kashanian, S.; Lucia, L.A.; Khazaei, M. Intrinsic parameters for the synthesis and tuned properties of amphiphilic chitosan drug delivery nanocarriers. J. Control. Release 2017, 260, 213–225. [Google Scholar] [CrossRef] [PubMed]
- Li, J.; Cai, C.; Li, J.; Li, J.; Li, J.; Sun, T.; Wang, L.; Wu, H.; Yu, G. Chitosan-based nanomaterials for drug delivery. Molecules 2018, 23, 2661. [Google Scholar] [CrossRef] [PubMed]
- Archana, D.; Dutta, J.; Dutta, P.K. Evaluation of chitosan nano dressing for wound healing: Characterization, in vitro and in vivo studies. Int. J. Biol. Macromol. 2013, 57, 193–203. [Google Scholar] [CrossRef]
- Tamer, T.M.; Collins, M.N.; Valachová, K.; Hassan, M.A.; Omer, A.M.; Mohy-Eldin, M.S.; Švík, K.; Jurčík, R.; Ondruška, Ľ.; Biró, C.; et al. MitoQ loaded chitosan-hyaluronan composite membranes for wound healing. Materials 2018, 11, 569. [Google Scholar] [CrossRef]
- Tamer, T.M.; Valachová, K.; Hassan, M.A.; Omer, A.M.; El-Shafeey, M.; Mohy Eldin, M.S.; Šoltés, L. Chitosan/hyaluronan/edaravone membranes for anti-inflammatory wound dressing: In vitro and in vivo evaluation studies. Mater. Sci. Eng. C 2018, 90, 227–235. [Google Scholar] [CrossRef]
- Valachová, K.; Tamer, T.M.; Eldin, M.M.; Šoltés, L. Radical-scavenging activity of glutathione, chitin derivatives and their combination. Chem. Pap. 2016, 70, i–viii. [Google Scholar] [CrossRef]
- Xie, F.; Ding, R.L.; He, W.F.; Liu, Z.J.L.; Fu, S.Z.; Wu, J.B.; Yang, L.L.; Lin, S.; Wen, Q.L. In vivo antitumor effect of endostatin-loaded chitosan nanoparticles combined with paclitaxel on lewis lung carcinoma. Drug Deliv. 2017, 24, 1410–1418. [Google Scholar] [CrossRef]
- Yildirim-Aksoy, M.; Beck, B.H. Antimicrobial activity of chitosan and a chitosan oligomer against bacterial pathogens of warmwater fish. J. Appl. Microbiol. 2017, 122, 1570–1578. [Google Scholar] [CrossRef]
- Omer, A.M.; Tamer, T.M.; Hassan, M.A.; Rychter, P.; Mohy Eldin, M.S.; Koseva, N. Development of amphoteric alginate/aminated chitosan coated microbeads for oral protein delivery. Int. J. Biol. Macromol. 2016, 92, 362–370. [Google Scholar] [CrossRef]
- Mi, F.L.; Tan, Y.C.; Liang, H.F.; Sung, H.W. In vivo biocompatibility and degradability of a novel injectable-chitosan-based implant. Biomaterials 2002, 23, 181–191. [Google Scholar] [CrossRef] [PubMed]
- Aranaz, I.; Alcántara, A.R.; Civera, M.C.; Arias, C.; Elorza, B.; Caballero, A.H.; Acosta, N. Chitosan: An overview of its properties and applications. Polymers 2021, 13, 3256. [Google Scholar] [CrossRef] [PubMed]
- Bakshi, P.S.; Selvakumar, D.; Kadirvelu, K.; Kumar, N.S. Chitosan as an environment friendly biomaterial—A review on recent modifications and applications. Int. J. Biol. Macromol. 2020, 150, 1072–1083. [Google Scholar] [CrossRef] [PubMed]
- Kedir, W.M.; Abdi, G.F.; Goro, M.M.; Tolesa, L.D. Pharmaceutical and drug delivery applications of chitosan biopolymer and its modified nanocomposite: A review. Heliyon 2022, 8, e10196. [Google Scholar] [CrossRef] [PubMed]
- Samani, S.M.; Ahmadi, F.; Oveisi, Z.; Amoozgar, Z. Chitosan based hydrogels: Characteristics and pharmaceutical applications. Res. Pharm. Sci. 2015, 10, 1. [Google Scholar]
- Wu, M.; Long, Z.; Xiao, H.; Dong, C. Recent research progress on preparation and application of N, N, N-trimethyl chitosan. Carbohydr. Res. 2016, 434, 27–32. [Google Scholar] [CrossRef]
- Tan, H.; Ma, R.; Lin, C.; Liu, Z.; Tang, T. Quaternized chitosan as an antimicrobial agent: Antimicrobial activity, mechanism of action and biomedical applications in orthopedics. Int. J. Mol. Sci. 2013, 14, 1854–1869. [Google Scholar] [CrossRef]
- Jiang, S.; Wang, L.; Yu, H.; Chen, Y. Preparation of crosslinked polystyrenes with quaternary ammonium and their antibacterial behavior. React. Funct. Polym. 2005, 62, 209–213. [Google Scholar] [CrossRef]
- Pignatello, R.; Leonardi, A.; Fuochi, V.; Petronio, G.P.; Greco, A.S.; Furneri, P.M. A method for efficient loading of ciprofloxacin hydrochloride in cationic solid lipid nanoparticles: Formulation and microbiological evaluation. Nanomaterials 2018, 8, 304. [Google Scholar] [CrossRef] [PubMed]
- Li, H.; Williams, G.R.; Wu, J.; Lv, Y.; Sun, X.; Wu, H.; Zhu, L.M. Thermosensitive nanofibers loaded with ciprofloxacin as antibacterial wound dressing materials. Int. J. Pharm. 2017, 517, 135–147. [Google Scholar] [CrossRef] [PubMed]
- Egorov, A.R.; Kurliuk, A.V.; Rubanik, V.V.; Kirichuk, A.A.; Khubiev, O.; Golubev, R.; Lobanov, N.N.; Tskhovrebov, A.G.; Kritchenkov, A.S. Chitosan-Based Ciprofloxacin Extended Release Systems: Combined Synthetic and Pharmacological (In Vitro and In Vivo) Studies. Molecules 2022, 27, 865. [Google Scholar] [CrossRef]
- Arauzo, B.; Lobera, M.P.; Monzon, A.; Santamaria, J. Dry powder formulation for pulmonary infections: Ciprofloxacin loaded in chitosan sub-micron particles generated by electrospray. Carbohydr. Polym. 2021, 273, 118543. [Google Scholar] [CrossRef] [PubMed]
- Cui, C.; Sun, S.; Li, X.; Chen, S.; Wu, S.; Zhou, F.; Ma, J. Optimizing the chitosan-PCL based membranes with random/aligned fiber structure for controlled ciprofloxacin delivery and wound healing. Int. J. Biol. Macromol. 2022, 205, 500–510. [Google Scholar] [CrossRef]
- Khan, Y.A.; Ozaltin, K.; Bernal-Ballen, A.; Di Martino, A. Chitosan-alginate hydrogels for simultaneous and sustained releases of ciprofloxacin, amoxicillin and vancomycin for combination therapy. J. Drug Deliv. Sci. Technol. 2021, 61, 102126. [Google Scholar] [CrossRef]
- Heydari, A.; Pardakhti, A.; Sheibani, H. Preparation and Characterization of Zwitterionic Poly(β-cyclodextrin-co-guanidinocitrate) Hydrogels for Ciprofloxacin Controlled Release. Macromol. Mater. Eng. 2017, 302, 1600501. [Google Scholar] [CrossRef]
- Pajor, K.; Pajchel, Ł.; Zgadzaj, A.; Kowalska, P.; Kowalczuk, A.; Kolmas, J. Ciprofloxacin-Loaded Composite Granules Enriched in Silver and Gallium Ions—Physicochemical Properties and Antimicrobial Activity. Coatings 2023, 13, 494. [Google Scholar] [CrossRef]
- Arif, W.; Rana, N.F.; Saleem, I.; Tanweer, T.; Khan, M.J.; Alshareef, S.A.; Sheikh, H.M.; Alaryani, F.S.; Al-Kattan, M.O.; Alatawi, H.A.; et al. Antibacterial Activity of Dental Composite with Ciprofloxacin Loaded Silver Nanoparticles. Molecules 2022, 27, 7182. [Google Scholar] [CrossRef]
- Syed Abdullah, S.S.; Faisul Aris, F.A.; Said Azmi, S.N.N.; Anak John, J.H.S.; Khairul Anuar, N.N.; Mohd Asnawi, A.S.F. Development and evaluation of ciprofloxacin-bacterial cellulose composites produced through in situ incorporation method. Biotechnol. Rep. 2022, 34, e00726. [Google Scholar] [CrossRef]
- Durgapal, S.; Mukhopadhyay, S.; Goswami, L. Preparation, characterization and evaluation of floating microparticles of ciprofloxacin. Int. J. Appl. Pharm. 2017, 9, 14183. [Google Scholar] [CrossRef]
- Singh, K.; Mishra, A.; Singh, A. Synthesis Characterization and In Vitro Release Study of Ciprofloxacin-Loaded Chitosan Nanoparticle. Bionanoscience 2018, 8, 229–236. [Google Scholar] [CrossRef]
- Sikorski, D.; Bauer, M.; Frączyk, J.; Draczyński, Z. Antibacterial and Antifungal Properties of Modified Chitosan Nonwovens. Polymers 2022, 14, 1690. [Google Scholar] [CrossRef] [PubMed]
- Pandey, S.; Pandey, P.; Tiwari, G.; Tiwari, R.; Rai, A.K. FTIR Spectroscopy: A Tool for Quantitative Analysis of Ciprofloxacin in Tablets. Indian J. Pharm. Sci. 2012, 74, 86–90. [Google Scholar] [CrossRef] [PubMed]
- Mafra, L.; Santos, S.M.; Siegel, R.; Alves, I.; Almeida Paz, F.A.; Dudenko, D.; Spiess, H.W. Packing interactions in hydrated and anhydrous forms of the antibiotic ciprofloxacin: A solid-state NMR, X-ray diffraction, and computer simulation study. J. Am. Chem. Soc. 2012, 134, 71–74. [Google Scholar] [CrossRef]
- Potrzebowska, N.; Cavani, O.; Kazmierski, S.; Wegrowe, J.E.; Potrzebowski, M.J.; Clochard, M.C. Molecular dynamics between amorphous and crystalline phases of e-beam irradiated piezoelectric PVDF thin films employing solid-state NMR spectroscopy. Polym. Degrad Stab. 2022, 195, 109786. [Google Scholar] [CrossRef]
- Pawlak, T.; Czajkowska-Szczykowska, D.; Jastrzebska, I.; Santillan, R.; Seroka, B.; Maj, J.; Morzycki, J.W.; Labra-Vázquez, P.; Farfán, N.; Bujacz, G.D.; et al. Influence of Hydrogen/Fluorine Substitution on Structure, Thermal Phase Transitions, and Internal Molecular Motion of Aromatic Residues in the Crystal Lattice of Steroidal Rotors. Cryst. Growth Des. 2020, 20, 2202–2216. [Google Scholar] [CrossRef]
- Skorupska, E.; Paluch, P.; Jeziorna, A.; Potrzebowski, M.J. NMR study of BA/FBA cocrystal confined within mesoporous silica nanoparticles employing thermal solid phase transformation. J. Phys. Chem. C 2015, 119, 8652–8661. [Google Scholar] [CrossRef]
- Muhamad Fauzi, N.I.; Fen, Y.W.; Abdullah, J.; Kamarudin, M.A.; Sheh Omar, N.A.; Kamal Eddin, F.B.; Ramdzan, N.S.M.; Daniyal, W.M.E.M.M. Evaluation of Structural and Optical Properties of Graphene Oxide-Polyvinyl Alcohol Thin Film and Its Potential for Pesticide Detection Using an Optical Method. Photonics 2022, 9, 300. [Google Scholar] [CrossRef]
- Almalik, A.; Donno, R.; Cadman, C.J.; Cellesi, F.; Day, P.J.; Tirelli, N. Hyaluronic acid-coated chitosan nanoparticles: Molecular weight-dependent effects on morphology and hyaluronic acid presentation. J. Control. Release 2013, 172, 1142–1150. [Google Scholar] [CrossRef]
- Fauzi, N.I.M.; Fen, Y.W.; Omar, N.A.S.; Saleviter, S.; Daniyal, W.M.E.M.M.; Hashim, H.S.; Nasrullah, M. Nanostructured chitosan/maghemite composites thin film for potential optical detection of mercury ion by surface plasmon resonance investigation. Polymers 2020, 12, 1497. [Google Scholar] [CrossRef]
- Rubina, M.; Elmanovich, I.; Vasil’kov, A. AFM Studies of Chitosan, Gold-Chitosan, and Silver-Chitosan Films Morphology. Macromol. Symp. 2020, 389, 1900068. [Google Scholar] [CrossRef]
- Rathore, H.S.; Senthilvelan, T.; Vasantharaja, R.; Abraham, L.S.; Prakash, D.; Sivagnanam, U.T.; Gupta, S. Fabrication and characterization of chitosan film impregnated ciprofloxacin drug: A comparative study. Biocatal. Agric. Biotechnol. 2019, 18, 101078. [Google Scholar] [CrossRef]
- Lewandowska, K.; Szulc, M. Rheological and Film-Forming Properties of Chitosan Composites. Int. J. Mol. Sci. 2022, 23, 8763. [Google Scholar] [CrossRef]
- Cazón, P.; Antoniewska, A.; Rutkowska, J.; Vázquez, M. Evaluation of easy-removing antioxidant films of chitosan with Melaleuca alternifolia essential oil. Int. J. Biol. Macromol. 2021, 186, 365–376. [Google Scholar] [CrossRef]
- Cuprys, A.; Maletskyi, Z.; Rouissi, T.; Ratnaweera, H.; Brar, S.K.; Knystautas, E.; Drogui, P. Insights into the simultaneous sorption of ciprofloxacin and heavy metals using functionalized biochar. Water 2021, 13, 2768. [Google Scholar] [CrossRef]
- Asadi, S.; Mortezagholi, B.; Hadizadeh, A.; Borisov, V.; Ansari, M.J.; Shaker Majdi, H.; Nishonova, A.; Adelnia, H.; Farasati Far, B.; Chaiyasut, C. Ciprofloxacin-Loaded Titanium Nanotubes Coated with Chitosan: A Promising Formulation with Sustained Release and Enhanced Antibacterial Properties. Pharmaceutics 2022, 14, 1359. [Google Scholar] [CrossRef] [PubMed]
- Afzal, M.Z.; Sun, X.F.; Liu, J.; Song, C.; Wang, S.G.; Javed, A. Enhancement of ciprofloxacin sorption on chitosan/biochar hydrogel beads. Sci. Total Environ. 2018, 639, 560–569. [Google Scholar] [CrossRef]
- Ma, W.; Dai, J.; Dai, X.; Yan, Y. Preparation and Characterization of Chitosan/Kaolin/Fe 3 O 4 Magnetic Microspheres and Their Application for the Removal of Ciprofloxacin. Adsorpt. Sci. Technol. 2014, 32, 775–790. [Google Scholar] [CrossRef]
- Abd El-Monaem, E.M.; Eltaweil, A.S.; Elshishini, H.M.; Hosny, M.; Abou Alsoaud, M.M.; Attia, N.F.; El-Subruiti, G.M.; Omer, A.M. Sustainable adsorptive removal of antibiotic residues by chitosan composites: An insight into current developments and future recommendations. Arab. J. Chem. 2022, 15, 103743. [Google Scholar] [CrossRef]
- Bagheri-Khoulenjani, S.; Taghizadeh, S.M.; Mirzadeh, H. An investigation on the short-term biodegradability of chitosan with various molecular weights and degrees of deacetylation. Carbohydr. Polym. 2009, 78, 773–778. [Google Scholar] [CrossRef]
- Rejane, C. Goy D de BOBGA. A Review of the Antimicrobial Activity of Chitosan. Polimeros 2009, 19, 241–247. [Google Scholar] [CrossRef]
- Qin, Y.; Li, P. Antimicrobial chitosan conjugates: Current synthetic strategies and potential applications. Int. J. Mol. Sci. 2020, 21, 499. [Google Scholar] [CrossRef] [PubMed]
- Amato, A.; Migneco, L.M.; Martinelli, A.; Pietrelli, L.; Piozzi, A.; Francolini, I. Antimicrobial activity of catechol functionalized-chitosan versus Staphylococcus epidermidis. Carbohydr. Polym. 2018, 179, 273–281. [Google Scholar] [CrossRef] [PubMed]
- Martins, A.F.; Facchi, S.P.; Follmann, H.D.M.; Pereira, A.G.B.; Rubira, A.F.; Muniz, E.C. Antimicrobial activity of chitosan derivatives containing N-quaternized moieties in its backbone: A review. Int. J. Mol. Sci. 2014, 15, 20800–20832. [Google Scholar] [CrossRef]
- Wei, L.; Tan, W.; Wang, G.; Li, Q.; Dong, F.; Guo, Z. The antioxidant and antifungal activity of chitosan derivatives bearing Schiff bases and quaternary ammonium salts. Carbohydr. Polym. 2019, 226, 115256. [Google Scholar] [CrossRef]
- Nagy, V. Chitosan-Natural Antioxidant Conjugates: Synthesis, Antimicrobial and Antioxidant Properties. Master’s Thesis, University of Iceland, Reykjavik, Iceland, 2018. [Google Scholar]
- Abd El-Hack, M.E.; El-Saadony, M.T.; Shafi, M.E.; Zabermawi, N.M.; Arif, M.; Batiha, G.E.; Khafaga, A.F.; Abd El-Hakim, Y.M.; Al-Sagheer, A.A. Antimicrobial and antioxidant properties of chitosan and its derivatives and their applications: A review. Int. J. Biol. Macromol. 2020, 164, 2726–2744. [Google Scholar] [CrossRef]
- Davis, R.; Markham, A.; Balfour, J.A.; Ball, P.; Peruana Cayetano Heredia, U.; Guay, D. Drug Evaluation Ciprofloxacin An Updated Review of Its Pharmacology, Therapeutic Efficacy and Tolerability. Drugs 1996, 51, 1019–1074. [Google Scholar] [CrossRef]
- Pangprasit, N.; Srithanasuwan, A.; Suriyasathaporn, W.; Pikulkaew, S.; Bernard, J.K.; Chaisri, W. Antibacterial activities of acetic acid against major and minor pathogens isolated from mastitis in dairy cows. Pathogens 2020, 9, 961. [Google Scholar] [CrossRef]
- Ryssel, H.; Kloeters, O.; Germann, G.; Schäfer, T.; Wiedemann, G.; Oehlbauer, M. The antimicrobial effect of acetic acid—An alternative to common local antiseptics? Burns 2009, 35, 695–700. [Google Scholar] [CrossRef]
- Salama, A.; Hasanin, M.; Hesemann, P. Synthesis and antimicrobial properties of new chitosan derivatives containing guanidinium groups. Carbohydr. Polym. 2020, 241, 116363. [Google Scholar] [CrossRef] [PubMed]
- Huang, L.; Dai, T.; Xuan, Y.; Tegos, G.P.; Hamblin, M.R. Synergistic combination of chitosan acetate with nanoparticle silver as a topical antimicrobial: Efficacy against bacterial burn infections. Antimicrob. Agents Chemother. 2011, 55, 3432–3438. [Google Scholar] [CrossRef] [PubMed]
- Sikorski, D.; Gzyra-Jagieła, K.; Draczyński, Z. The kinetics of chitosan degradation in organic acid solutions. Mar. Drugs 2021, 19, 236. [Google Scholar] [CrossRef] [PubMed]
- Jiang, L.; Wang, F.; Han, F.; Prinyawiwatkul, W.; No, H.K.; Ge, B. Evaluation of diffusion and dilution methods to determine the antimicrobial activity of water-soluble chitosan derivatives. J. Appl. Microbiol. 2013, 114, 956–963. [Google Scholar] [CrossRef]
- Czechowska-Biskup, R.; Jarosińska, D.; Rokita, B.; Ulański, P.; Rosiak, J.M. Determination of degree of deacetylation of chitosan-comparision of methods. Prog. Chem. Appl. Chitin Its Deriv. 2012, 17, 5–20. [Google Scholar]

| Sample Symbol | Escherichia coli ATCC 8739 | Staphylococcus aureus ATCC 6538 |
|---|---|---|
| CS 1 | 0 | 0 |
| CS 2 | 0 | 0 |
| CS 3 | 0 | 0 |
| CS 4 | 0 | 0 |
| CS 5 | 0 | 0 |
| CS 6 | 30 | 0 |
| CS 1C | 45 | 36 |
| CS 2C | 47 | 36 |
| CS 3C | 50 | 36 |
| CS 4C | 52 | 36 |
| CS 1G | 24 | 0 |
| CS 2G | 0 | 0 |
| CS 3G | 0 | 0 |
| CS 4G | 0 | 0 |
| CS 5G | 24 | 0 |
| CS 6G | 32 | 0 |
| CS 1CG | 58 | 45 |
| CS 2CG | 60 | 60 |
| Control—ciprofloxacin 32 μg/mL | 42 | 31 |
| Lp | Sample Name | Mn, g/mol | Mw g/mol | Mw/Mn | Description |
|---|---|---|---|---|---|
| 1 | CS 1 | 94,700 | 209,500 | 2.21 | without modifications |
| 2 | CS 2 | 13,600 | 28,900 | 2.12 | without modifications |
| 3 | CS 3 | 5380 | 154,200 | 2.87 | without modifications |
| 4 | CS 4 | 85,700 | 216,200 | 2.52 | without modifications |
| 5 | CS 5 | 113,100 | 189,800 | 1.68 | without modifications |
| 6 | CS 6 | 53,900 | 129,200 | 2.40 | without modifications |
| 7 | CS 1C | - | - | - | Ciprofloxacin modification |
| 8 | CS 2C | - | - | - | Ciprofloxacin modification |
| 9 | CS 3C | - | - | - | Ciprofloxacin modification |
| 10 | CS 4C | - | - | - | Ciprofloxacin modification |
| 11 | CS 1G | - | - | - | modification with acetic acid vapors |
| 12 | CS 2G | - | - | - | modification with acetic acid vapors |
| 13 | CS 3G | - | - | - | modification with acetic acid vapors |
| 14 | CS 4G | - | - | - | modification with acetic acid vapors |
| 15 | CS 5G | - | - | - | modification with acetic acid vapors |
| 16 | CS 6G | - | - | - | modification with acetic acid vapors |
| 17 | CS 1CG | - | - | - | Ciprofloxacin modification and subsequent modification with acetic acid vapors |
| 18 | CS 2CG | - | - | - | Ciprofloxacin modification and subsequent modification with acetic acid vapors |
Disclaimer/Publisher’s Note: The statements, opinions and data contained in all publications are solely those of the individual author(s) and contributor(s) and not of MDPI and/or the editor(s). MDPI and/or the editor(s) disclaim responsibility for any injury to people or property resulting from any ideas, methods, instructions or products referred to in the content. |
© 2023 by the authors. Licensee MDPI, Basel, Switzerland. This article is an open access article distributed under the terms and conditions of the Creative Commons Attribution (CC BY) license (https://creativecommons.org/licenses/by/4.0/).
Share and Cite
Sikorski, D.; Rosiak, P.; Janczewski, Ł.; Potrzebowski, M.J.; Kregiel, D.; Kaźmierski, S.; Neubauer, D.; Kolesińska, B.; Frączyk, J.; Adamczyk, A.; et al. Synthesis and Characterization of Antibacterial Chitosan Films with Ciprofloxacin in Acidic Conditions. Int. J. Mol. Sci. 2023, 24, 15163. https://doi.org/10.3390/ijms242015163
Sikorski D, Rosiak P, Janczewski Ł, Potrzebowski MJ, Kregiel D, Kaźmierski S, Neubauer D, Kolesińska B, Frączyk J, Adamczyk A, et al. Synthesis and Characterization of Antibacterial Chitosan Films with Ciprofloxacin in Acidic Conditions. International Journal of Molecular Sciences. 2023; 24(20):15163. https://doi.org/10.3390/ijms242015163
Chicago/Turabian StyleSikorski, Dominik, Piotr Rosiak, Łukasz Janczewski, Marek J. Potrzebowski, Dorota Kregiel, Sławomir Kaźmierski, Damian Neubauer, Beata Kolesińska, Justyna Frączyk, Anna Adamczyk, and et al. 2023. "Synthesis and Characterization of Antibacterial Chitosan Films with Ciprofloxacin in Acidic Conditions" International Journal of Molecular Sciences 24, no. 20: 15163. https://doi.org/10.3390/ijms242015163
APA StyleSikorski, D., Rosiak, P., Janczewski, Ł., Potrzebowski, M. J., Kregiel, D., Kaźmierski, S., Neubauer, D., Kolesińska, B., Frączyk, J., Adamczyk, A., & Draczyński, Z. (2023). Synthesis and Characterization of Antibacterial Chitosan Films with Ciprofloxacin in Acidic Conditions. International Journal of Molecular Sciences, 24(20), 15163. https://doi.org/10.3390/ijms242015163

